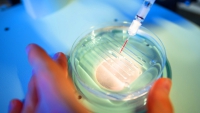
Imagen Ilustrativa

Ciencia y Tecnología
Un enigma en el corazón del desierto En el desierto del Néguev, donde la arena y el sol abrasador imponen sus propias reglas, se encuentra uno de los sitios más resguardados y misteriosos del mundo: el Centro de Investigación Nuclear de Dimona.
Se trata de un elemento potencialmente valioso en el trabajo con personas propensas a la irritabilidad, el mal genio o la violencia, aseguran los científicos.
Según los investigadores, este nuevo proceso es capaz de actuar sin afectar el resto del material genético.
Más...
Los metadatos apuntaron a clientes de diferentes partes del mundo, como Estados Unidos, Europa, Oriente Medio y Australia.
Durante el conflicto de 12 días con Irán en junio de 2025, Estados Unidos enfrentó una grave escasez de interceptores para el sistema de defensa antimisiles THAAD (Defensa Terminal de Área a Gran Altitud).
Más de 70 buques se encuentran en distintas fases de preparación en los astilleros rusos y también está prevista la construcción de seis nuevos submarinos nucleares de aquí a 2030.